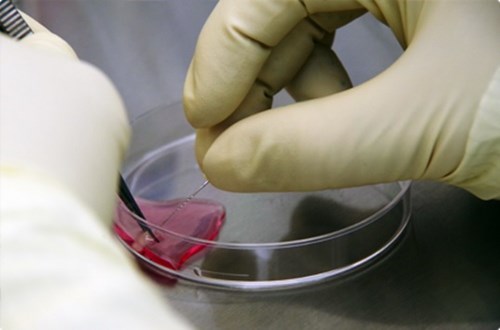

Theo phía chúng tôi điều tra, một viện thẩm mỹ có trụ sở tại Nhật Bản – Dr. Eri International đang cáo buộc đối tác Việt Nam có động thái có thê gây hại cho khách hàng khi áp dụng phương pháp làm đẹp bằng tế bảo gốc có nguồn gốc từ thỏ.
Ngày nay, ngành công nghiệp làm đẹp Việt Nam nói riêng và thế giới nói chung đã phát triển vượt bậc. Song, mặt trái của loại dịch vụ này cũng khiến dư luận bàng hoàng.
Mới đây, chúng tôi mới có thông tin rằng một trong những viện thẩm mỹ nổi tiếng tại Nhật bản là Dr. Eri Group đang tiếp tục cáo buộc phía đối tác Việt Nam có những hành vi vi phạm nghiêm trọng tiêu chuẩn y học.

Mọi chuyện bắt nguồn từ việc Dr. Eri Group đang cáo buộc phía Công ty đối tác Việt Nam rằng họ đã tiêm tế bào gốc thỏ một cách bất hợp pháp cho khách hàng mà chưa có được sự đồng ý của họ.
Theo thông tin điều tra của chúng tôi cho thấy mặc dù họ nhận thức một cách đầy đủ về sự nguy hiểm và mặc dù phía Dr. Eri Group đã nhiều lần yêu cầu phía Đối tác Việt Nam dừng ngay việc đó lại, nhưng việc đó vẫn tiếp diễn trong suốt năm 2020 tại các chi nhánh của Đối tác Việt Nam.
Thực tế, phương pháp tiêm tế bào gốc của động vật vào cơ thể người là chuyện cực kỳ nguy hiểm, thậm chí có nguy cơ đe dọa đến tính mạng. Do đó, việc tiêm tế bào gốc thỏ trên cơ thể người tuyệt đối bị cấm tại nhiều nước phát triển trên thế giới.
Đồng thời, có rất nhiều nghiên cứu, bao gồm cả nghiên cứu của các cơ sở y tế trên thế giới về sự gây hại một cách rõ ràng đối với cơ thể người bằng việc cố tình tiêm tế bào gốc động vật bao gồm nhưng không giới hạn trong việc làm tắc mạch máu.
Thông tin điều tra của chúng tôi cũng cho thấy rằng phía Dr. Eri Group có khả năng đang nắm trong tay đầy đủ bằng chứng, trong đó có 2 file ghi âm của nhân viên bán hàng của đối tác Việt Nam tại các chi nhánh. Tại đó, họ tư vấn cho các khách hàng của họ tiêm tế bào gốc thỏ với giá 29.000.000 đồng/một ống. Ngoài ra, Dr. Eri Group cũng có vẻ như đang có trong tay file ghi âm của bác sỹ đã từng làm việc tại clinic tại thời điểm họ áp dụng phương pháp tiêm tế bào gốc thỏ cho khách hàng tại Clinic.

Chúng tôi đã đề nghị phỏng vấn đại diện của phía Dr. Eri Group, tuy nhiên, chưa nhận được bất kỳ phản hồi nào từ đại diện từ phía Việt Nam cũng như từ phía Nhật Bản. Vì thế, chúng tôi sẽ tiếp tục điều tra vì điều này có thể dẫn đến nguy cơ đe dọa đến tính mạng cho một số khách hàng/bệnh nhân tại các phòng khám liên quan. Chúng tôi sẽ cập nhật cho Quý độc giả khi chúng tôi có thêm thông tin. Vụ việc đang gây xôn xao giới làm đẹp tại Việt Nam. Việc tiêm tế bào gốc thỏ vào cơ thể người là vụ scandal y học mà Bộ Y tế nên/cần phải điều tra.